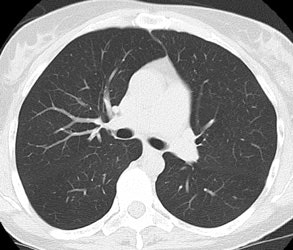
Screening Lung

Why Screen for Lung Cancer?
The purpose of screening is to prevent or delay, by means of earlier detection, the development of advanced disease and its adverse effects [20]. Approximately 170,000 to 175,000 new cases of lung cancer are diagnosed in the United States each year [34,35]. Approximately 154,900 to 160,400 patients will die as a result of the disease over the course of the next year [2,35]. Bronchogenic carcinoma is the most common cause of cancer death in men and women both in the United States and worldwide [1,3]. In the US, lung cancer accounts for 32% of cancer deaths in men and 25% of cancer deaths in women [2]. The number of deaths from lung cancer exceeds the total number of deaths from breast, colon, prostate, and cervical cancer [35]. Overall survival for lung cancer is very poor- over the past 20 years 5-year survival has improved from 14.5% to only 16.3% [32]. The poor survival is because many patients present with advanced disease- distant spread in found in about 52% and regional spread in 29% at time of presentation [32]. Lung cancer also places a tremendous burden on the health care system with an estimated cost for treatment in the US in 2004 of $9.6 billion [74].
The prognosis for lung cancer depends on a number of variables, but one of the most important factors is the TNM stage at presentation. Patients with Stage IA lesions (less than 3 cm in size and no lymph node or distant metastases) have a 5 year survival of 67% to 80% [15-17]. The outcome in patients who decline treatment for stage I cancers is almost universally fatal [34]. Therefore, it would be desirable to identify patients with early stage lung cancer in an attempt to improve long term survival.
CXR screening has not been recommended, but many physicians will order yearly CXR's on their patients- particularly smokers or ex-smokers. The prostate, lung, colorectal, and ovarian randomized trial demonstrated no reduction in lung cancer mortality in patients screened with CXR compared to usual care (however, only a baseline and 3 annual followup screening exams were performed) [87]. Routine chest radiology has a low diagnostic yield and false positive findings on CXR often lead to unnecessary work-up at additional costs [42]. Worse is that up to 90% (19-90%) of cancers will go undetected on the patient's initial CXR. Even when aware that they are reviewing films with missed cancers, radiologists will fail to detect up to 40% of the lesions [73]. In a recent review, the median diameter of missed cancers on CXR was 1.9 cm and even lesions of 3 cm or greater in size can be missed [32]. In another study comparing digital CXR to CT, 22-63% of the lung cancers would have been missed on CXR at a stage of disease at which they could be detected with CT (and in this study readers were aware that the CXR's to be reviewed were of patients with documented cancer by CT) [81]. Commonly, lesions that are missed on CXR are obscured by overlying anatomic structures such as the ribs or clavicle [32]. In various studies, lung cancers were obscured by bone structures in 22-95% of cases [85]. Dual energy subtraction radiographs may aid in the detection of lung cancers [75]. Dual energy exams can distinguish bone from soft tissue and permit subtraction of the overlying osseous structures permitting improved conspicuity of lung lesions [75]. One potential drawback is that subtraction can sometimes have a detrimental effect by rendering a lesion less apparent [75]. Temporal subtraction imaging of digital radiographs, although somewhat limited by mis-registration artifacts, may also improve the diagnostic accuracy of CXR's [63]. Other bone suppression software is also available and has been reported to increase detection of lung nodules and cancers [85]. Computer aided detection (CAD) has also been studied to improve lung cancer detection, but results in a large number of false-positive marks per radiograph [73,82]. Additionally, detection of subtle cancers has not been shown to be improved because observers tend to reject the annotation as a false-positive [82].
Studies have demonstrated that helical CT is clearly superior to CXR for the identification of small pulmonary nodules [4,6,11]. Several authors have studied the impact of helical CT for lung cancer screening.
|
Positive lung cancer screening exam: The patient shown below had undergone lung screening CT in 2002 (left image). The patient was lost to follow-up, but returned for a repeat screening exam in 2007. The 2007 (right image) exam revealed a new stage I NSCLC in the right apex. There is a small linear scar in the medial left apex. |
|
|
CT Lung Cancer Screening Studies:
National Lung Screening Trial
This study prospectively evaluated over 50,000 patients
considered to be at high risk for lung cancer (asymptomatic
patients age 55-74 years, at least 30 pack-years, current or
former smokers that had stopped < 15 years earlier) and
randomized participants to screening with either CXR or low dose
CT [88]. Study participants underwent three screening exams
performed at one year intervals [88]. The estimated average
effective dose from the screening CT exam was 1.5 mSv [88]. Other
authors indicate that the male dose was 1.6 mSv and the female
dose was 2.1-2.4 mSv [89]. The incidence of cancer in the CT group
was about 4% [88]. LDCT detected malignant disease 4 times more
frequently than CXR [104]. The study also demonstrated a relative
reduction in mortality from lung cancer with low-dose screening CT
of 20%, compared to the CXR group [88,104].
Early Lung Cancer Action Project (ELCAP) [6]:
A New York study. Enrolled 1000 asymptomatic subjects aged 60 years or older, with at least 10 pack-years of cigarette smoking and no previous cancer, who were medically fit to undergo thoracic surgery. Patients were imaged using a low dose helical CT exam- 140 kVp, 40 mA, collimation 10 mm, pitch 2. Only lung windows were reviewed for screening. Nodules were detected in 56% of patients enrolled in the study. Non-calcified nodules were detected in 233 patients (23%) on initial low-dose CT (compared with 68 (7%) by chest radiography). For all patients with non-calcified nodules a diagnostic CT scan with thin slices through the nodule was performed. Non-calcified nodules less than 5 mm in size were re-evaluated at 3, 6, 12, and 24 months for change in size or morphologic characteristics. Change in lesion size was determined using a volumetic evaluation. Non-calcified nodules larger than 11 mm were biopsied or resected via VATS.
There were 31 prevalence cancers detected, but 2 were endobronchial and 2 were mediastinal- these 4 cases were excluded from the study which focused on parenchymal lesions. There were 27 cancers in the 223 non-calcified parenchymal nodules detected on CT (CXR detected only 7 of these lesions). Of the 27 cancers detected, 22 were Stage IA and one was Stage IB. Cancer was detected in 14 nodules less than 1 cm in size. Initial screening CT or initial diagnostic exam revealed 13 of the 27 cancers, and 14 (52% of cancers) were detected based upon interval growth on follow-up imaging. During the study, 28 nodules were biopsied and 27 of these were malignant lesions. Three individuals underwent biopsy against the ELCAP recommendations and all had benign non-calcified nodules. No participant had thoracotomy for a benign nodule. The study revealed that the likelihood for lung cancer in a patient with two to six lung nodules was not appreciably lower than that for a patient with a solitary non-calcified nodule. Thus, although current practice tends to discount the likelihood of primary malignant disease when more than one non-calcified nodule is seen, this study would suggest otherwise. Part solid nodules identified on screening CT exams may have a higher likelihood for being malignant (particularly bronchoalveolar cell and adenocarcinoma) [22].
Follow-up data [7]: A total of 1184 annual repeat low dose CT screenings were performed. Images were reconstructed with overlapping 5-mm intervals and lung and mediastinal windows were viewed. Discrete "ground-glass opacities" were considered to be nodules. Positive findings were identified in 63 cases. In 32 of these 63 cases, the nodule was retrospectively identified on the previous low dose screening exam (51% of these nodules were initially missed). Of the missed nodules, 23 were stable and 9 had enlarged from the baseline screening exam. In 10 of the 63 positive cases a dedicated CT scan rendered the result of the screening test as negative (ie: no nodule or more than 6 nodules). Therefore, a new nodule was detected in 30 cases (2.5%) (63 nodules minus 23 stable nodules minus 10 findings negated by dedicated CT). In all cases of a positive screening result, patients received a course of broad-spectrum antibiotics, followed by a repeat exam in one month to assess for change. In 22 of the 30 cases the patients abnormality either resolved or remained stable (2 patients died of unrelated causes). In 8 patients the nodule demonstrated further growth and was then biopsied. There were 7 cancers (5 were Stage IA, one Stage IIIA [a 5 mm adenocarcinoma with mediastinal nodal metastases], and one lesion was limited small cell cancer). Of the 7 cancers detected, 3 could be clearly identified and one possibly on the initial screening exam. Two patients developed symptomatic cancers that were endobronchial between scans- one of these lesions could be identified in retrospect on the patients initial screening exam. Therefore, 5 of 9 cancers (56%) that developed in the screening population were missed on the patients initial screening exam.
The data from the ELCAP study indicate that although false-positive exams are common on the baseline study- this is not the case for the followup exams [45].
NY ELCAP [70]:
Screened 6295 asymptomatic volunteers between June 2000 and Feb 2003. Patients were at least 60 years of age and had at least a 10-pack year smoking history [70]. An exam was considered positive if a solid or semi-solid nodule at least 5 mm in diameter or a non-solid nodule at least 8 mm in diameter were detected- 14.4% of patients had a positive result on initial baseline exam [70]. A semi-positive result was defined as a solid or part-solid nodule less than 5mm, or a non-solid nodule less than 8 mm- 27.4% of patients had a semi-positive finding for which a follow-up screening exam in one year was recommended [70]. There were 134 recommendations for biopsy and total of 125 patients were diagnosed with malignancy (93%)- 121 with lung cancer, 2 with metastases, and 2 with lymphoma [70]. 101 patients were diagnosed with lung cancer as a result of the baseline screening exam and 91% of these patients had no clinical evidence of lymph node metastases when recommended for biopsy [70]. Twenty patients were diagnosed with lung cancer at repeat screening and 85% of these patients had no clinical evidence of lymph node metastases [70]. Three patients at repeat screening had metastatic disease and all had small cell lung cancer [70]. Three patients were diagnosed with lung cancer between screening exams when they presented due to clinical symptoms [70]. The overall prevalence of lung cancer in the study population was 1.6% [70]. There were no surgical mortalities [70]. The overall estimated 10 year survival was 80%, while the 10 year survival for patients with stage I cancer that underwent prompt surgical resection was estimated to be 92% [70].
Diederich et al [21]:
Screened 817 asymptomatic smokers aged 40-78 years (median 53 years) with a median tobacco consumption of 45 pack-years [21]. Used a low-dose helical CT exam with 5 mm collimation and 10 mm per rotation table feed [21]. At least one non-calcified pulmonary nodule was detected in 43% of patients [21]. Lesions larger than 10 mm were classified as "potentially" malignant; however, it was decided individually whether the lesion was more likely benign or malignant on the basis of its morphology and associated findings (eg, calcified hilar or mediastinal nodes) [21]. Following initial screening, biopsy was performed in 12 patients with nodules larger than 1 cm that had features suggestive of malignancy. Malignancy was diagnosed in 10 of these patients (one patient had two cancers) [21]. One nodule that was felt to represent a scar at initial screening demonstrated interval growth and was found to be a stage I adenocarcinoma [21]. Therefore, there were a total of 12 malignancies diagnosed in 11 patients [21]. The prevalence of malignancy was 1.3% [21]. No tumor was detected in patients under the age of 50 years [21]. Of the 12 malignancies, 7 were stage I lesions (six IA and one IB) - roughly 58% [21].
Mayo Clinic experience [27,34]:
Enrolled 1520 participants who were at least 50 years old, had at least a 20 pack year smoking history, and if they were no longer smokers, had quit within the previous decade. There were one or more non-calcified pulmonary nodules identified in 51% of participants- 40% of the nodules were smaller than 4 mm. Three year follow up data- have detected a total of 41 lung cancers (1.4% of all nodules) - 59% were stage IA (mean diameter 17 mm). Twenty-six cancers were detected on the baseline exam (prevalence) and 10 were detected during follow-up (incidence) [34]. Eight patients had surgery for removal of a benign nodule (representing approximately 20% of operations performed). Five of these nodules demonstrated interval growth [34]. There was no surgical or perioperative mortality in any of these patients [34]. Of nodules less than 7 mm in size, less than 1% were found to be malignant [51].
Follow-up annual CT revealed one or more new nodules in 14% (1st year) and 9% (2nd year) of patients that were not present on the baseline exam [34]. During 3-years of follow-up, non-calcified pulmonary nodules were identified in 69% of participants [34].
Nearly 50% of participants had a significant ancillary finding (renal cancer, aortic aneurysm, etc) and nearly 80% had one or more positive findings that required further diagnostic imaging.
A five year follow-up 68 cancers were diagnosed in 66 patients (31 initial, 34 subsequent, and 3 interval cancers) - this represents 4% of partcipants [47]. When compared with the Mayo Lung Project, there was a substantially larger percentage of stage IA cancers detected with CT versus CXR [47]. Sixty-one percent of incidence non-small cell lung cancers were stage I, compared to the usual clinical practice in which about 20% of patients present with stage I disease [47]. However, there was no difference in the incidence lung cancer mortality rates between the two studies in the subset of men over age 50 years [47].
Cancer Research Campaign [4]:
In 1996, screened 5483 patients from the general population
between the age of 40-74 years using a low dose helical CT (120
kVp, 50 mA, 10 mm collimation, pitch 2). Both smokers and
non-smokers were screened. Detected 18 lung cancers (0.48% of
patients) of which 16 were Stage I cancers (89%). CXR was positive
in only 4 of the 18 patients. CT missed one cancer detected by
sputum cytology. 14 of the lung cancers occurred in non-smokers
which formed the larger portion of the screened population.
Parenchymal lung abnormalities were detected in 36% of patients. The majority of these could be classified as healed (or inactive) lesions or probably non-cancerous. 223 patients (4% of those screened) had abnormalities which were classified as indeterminate or suspicious for lung cancer. Diagnostic scans were performed in patients with suspicious lesions. If the CT findings did not strongly suggest cancer, a re-examination was recommended after 3 months, 6 months, 12 months, 18 months, and 24 months to assess for change in size or morphologic characteristics.
Follow-up data [5]: Repeat annual scans for most subjects were performed in 1997 and 1998, with a total of 13,786 scans taken during 1996-1998. In 1997, suspicious nodules were detected in 173 (3.9%) of 4425 scans and 25 (14%) of 173 were cancer. In 1998, suspicious nodules were detected in 136 (3.5%) of 3878 scans and 9 (7%) of 136 were cancer, respectively. For the entire study to date, 88% (55/60) of lung cancers identified on screening and surgically confirmed were Stage IA lesions.
Anti-lung Cancer Association Study (ALCA) [10,11,12]:
ALCA is a Japanese for-profit organization established in 1975 for screening lung cancer. Ninety-two percent of members enrolled in the service are heavy smokers with a mean age of about 60 years. In September 1993, ALCA introduced low-dose spiral CT screening to detect lung cancer in its early stages [11]. As part of their evaluation, patients underwent low dose CT screening using the following parameters: 120 kVp, 50 mA, 10 mm collimation, pitch 2. Between 1993 and 1996, lung cancer was detected by the ALCA in 22 patients out of a population of 1,443 persons who underwent screening. CXR failed to detect 73% of cancers detected on low dose helical CT. Of the 22 lung cancers, seven (32%) had been missed on initial spiral CT screening. Of the missed cancers, 6 were Stage I and one was Stage II.
Follow-up data: From 1993 to 1998, 1669 individuals have undergone biannual screening for lung cancer. Lung cancer has been detected in 31 of 9993 examinations (0.3%). Twenty-two of 24 cancers detected by CT were Stage IA. CXR failed to detect 77% of lesions identified on screening helical CT exams [10].
Nawa et al- Occupational health screening program [24]:
Screened 7,956 smokers and non-smokers over the age of 50 years. Non-calcified SPN's were detected in 26.3% of patients. Detailed evaluation was performed of all nodules greater than or equal to 8 mm in size. These nodules were then re-evaluated at 3, 6, and 12 months. Nodules less than 8 mm were directed to yearly screening. From initial screening and follow-up 51 patients went to thoracotomy (or VATS). Lung cancer was confirmed in 36 patients (prevalence 0.44%) and 78% of the tumors were stage IA. There were 10 false positive cases- focal fibrosis, foreign body granuloma, and subpleural lymphoid tissue.
Repeat screening yielded 4 additional tumors- 3 of which (75%) could be identified retrospectively. Three of the 4 cancers detected on follow-up screening were Stage IA and one was Stage IB.
Only 17 of the total of 40 cancer patients (42.5%) were smokers or former smokers. Twelve patients had bronchoialveolar cell carcinoma, and 9 of these cases occurred in non-smokers. The high incidence of lung cancer in non-smokers raises some interesting possibilities with regards to the natural history of lung cancer [68]. It may be that screening detects some tumors that are different from those that present clinically and that some of these cancers (well-differentiated adenocarcinomas) may never have caused symptoms or death [68]. Screening CT detected unsuspected neoplasms within the thyroid, parathyroid, mediastinum, and chest wall in 14 patients.
Matsumoto Research Center Screening Program [29]:
Performed 17,892 screening studies in a population consisting of both smokers and non-smokers. Mean age was 61 years. There were 83 cancers in the study population- 1% incidence of cancer in smokers and 1% incidence in non-smokers. Of the detected cancersm 80% were Stage IA. 32 of the cancers were missed on the initial screening CT exam (39%).
Screening population and at what interval?:
In general, it is desirable to
screen a patient population that would be expected to have a
high prevalence of disease- ie: patients that are at increased
risk for developing lung cancer. The average prevalence for
lung cancer in most screening studies is between 0.3-2.3%
[74]. Cigarette smoking is the overwhelming dominant risk
factor for developing lung cancer [54]. Cigarette smoking
causes more than 80% of lung cancers [77]. The relative risk
for developing lung cancer in a male smokers is about 10 times
that for non-smokers and the incidence of lung cancer directly
correlates with the pack-years of cigarettes smoked (heavy
smokers risk is 15-35 times greater) [45,54]. Generally,
screening studies have focused on patients with smoking
histories of 10-20 pack years or greater and for patients that
were at least 50 years of age. COPD increases the risk for
lung cancer by a factor of 2-3 [28]. Another risk factor is
occupational exposure to carcinogens (such as asbestos,
uranium, radon, arsenic, chromium, nickel, or mustard gases)
[54]. A history of lung cancer in a first degree relative is
also a risk factor (and may indicate a specific lung cancer
susceptibility gene) [54].
The National Comprehensive
Cancer Network recommends annual CT screening for two groups
of high risk individuals [99,104]:
Group 1:
- Age 55 to 74-80 years
- 30 pack year or more smoking history
- Current of former smokers who quit within the past 15 years
Group 2:
- Over 50 years of age
- Over 20 pack year smoking history
- Current or former smokers who quit for any length of time
- At least one additional risk factor (excluding second hand
smoke exposure): Personal history of smoking related cancer;
family history of lung cancer in a first degree relative;
chronic lung disease including emphysema and pulmonary
fibrosis; or known exposure to pulmonary carcinogens
An appropriate screening
interval has not yet been established. In a clinical setting
at this time, yearly screening is probably reasonable,
however, it should be understood that some cancers will become
evident between the screening studies [7]. One suggestion is
to perform a minimum of two annual screening exams followed by
repeat screening every 2-3 years thereafter [56].
Screening Protocol and Radiation Dose:
Radiation dose is directly proportional to tube current (mA) at a constant peak tube voltage (kVp), slice width, and pitch [26]. Helical CT screening employs the use of a low dose exam (click to view protocols) that adjusts mA, kVp, and pitch. The potential benefit of low dose CT for the detection of early lung cancer must be weighed against any possible risk of inducing malignancy by using ionizing radiation [21]. All screening exams utilize a decreased kVp and mA in order to decrease the radiation dose to the patient. The radiation exposure to the lungs is approximately 3 to 10 times higher than that of a two view plain film CXR (single view 3.2 mrem [25]), but is only one-sixth that of a conventional CT [10,33]. The dose to the breasts is equivalent to that of one mammographic film of each breast [33]. The average effective dose has been reported to be 0.6 mSv (60 mrem) in men and 1.1 mSv (110 mrem) in women [21]. These doses do not include any high resolution or follow-up CT studies. The dose for follow-up thin slice exams can be decreased by using lose dose parameters and limiting the exam to the area of the nodule [21]. To put the dose in perspective, natural background radiation exposes the average American to 360 mrem per year (470 mrem if living in Denver) and the radiation dose from a lumbar spine series (5 views) is approximately 200 mrem [25]. One must also keep in mind that human cells can repair low dose radiation cell damage rapidly [25]. Another way to look at radiation risk is in terms of things associated with a one in a million chance of dying: Receiving 10 mrem of radiation; smoking 1.4 cigarettes; eating 40 tablespoons (600 mL) of peanut butter; spending 2 days in New York City; driving 40 miles in a car; and flying 2500 miles in a jet [25].
|
Screening versus diagnostic CT imaging: The left image is from a low dose lung screen CT scan. The right image is from a diagnostic chest CT. Although the screening exam is slightly more noisy and not good for evaluation of soft tissue structures, the exam is of more than adequate diagnostic quality for evaluation of the lung parenchyma. |
|
|
The Committee on the Biological
Effects of Ionizing Radiation (BEIR V) estimated that the risk
of cancer death is 0.04% per rem of effective body dose [25].
BEIR VII estimated the overall chance of a radiation induced
solid tumor fatality from a 10 mGy (1 rad) CT exam to be about
0.00041- which is a very small risk [64]. This data was based
upon information from therapeutic high-dose radiation and from
survivors of the atomic bombs in Japan [25]. In determining
radiation risks from screening CT exams one assumes that there
is no threshold needed for cancer induction (stochastic
effect) and that high-dose data can be applied to low dose
studies [25]. Estimates by the International Commission on
Radiological Protection predict that examination of 100,000
individuals with one low dose CT exam will induce three (men)
to six (women) additional cancers within the next 15 to 20
years [21]. The likelihood for inducing malignancies in theory
increases with every additional thin-section follow-up CT or
annual repeat exam [21]. A 50 year old female smoker who
underwent annual CT lung screening until age 75 would incur an
estimated radiation related lung cancer risk of 0.85% in
addition to her otherwise expected lung cancer risk of
approximately 17% (men would incur a 0.23% increased risk)
[37]. It has been estimated that a mortality benefit of
greater than 5% may be necessary to outweigh the potential
radiation risks associated with screening [37]. This would
seem very possible given that by using screening CT, the
likelihood for detecting early stage lung cancer is also
increased [6,7]. In the end, the risk for inducing malignancy
must be balanced against the detection rate of potentially
curable cancer (between 600 to 800 cases of Stage I cancer per
100,000 screened individuals assuming a prevalence of only 1%)
[6,7,21]. Identification of the proper patient cohort for
screening is essential for minimizing radiation risks while
maximizing the gain from early lung cancer detection. Some
ways to reduce overall radiation risk would be to begin
screening at age 60 years, or screen every two years, rather
than annually [37]. Also- follow-up studies can be
performed with adjustment to the scanning parameters based upon
the patients weight in order to decrease patient radiation
exposure (i.e.: 70 mAs for a 70 kg patient) [60].
The use of breast shields in screening CT has been evaluated
and although there is an associated dose reduction, the authors
note that because a breast shield increases noise in the
anterior lung, faint and small nodules with ground-glass opacity
may be missed [94].
Radiologic guidelines:
Nodules identified on screening
CT should be defined based upon their characteristics of size,
shape, margins, location, and if benign calcifications are
present. Lung-RADS, from the ACR, is an established set of
guidelines for reporting and monitoring nodules detected on
lung screen CT [104]. Unfortunately, there is variability in
application of these guidelines with disagreement in some
specific scenarios [104]. It has also been reported that
subsolid nodules that are classified as category 2 or 3 have a
higher risk of malignancy than that which should ordinarily be
associated with those categories (3% vs 1% for category 2, and
13% vs 1-2% for category 3) [106]. Ground glass nodules
measuring 10-19 mm have a higher rate of malignancy compared
to GGNs smaller than 10 mm (6% vs 1.3%), despite both being
classified as category 2 [106]. Lung-RADS version 1.1 defines
benign perifissural nodules (PFNs) as a category 2
classification with a less than 1% probability of malignancy-
benign features as a solid PFN include smooth margins; an
oval, lentiform, or triangular shape; and a maximum diameter
less than 10 mm (or a volume less than 524 mm2)
[107]. Additionally, some specific scenarios are not addressed
by Lung-RADS including isolated hilar or mediastinal
adenopathy or pleural effusion in the absence of a lung nodule
[104].
In one study, only 2.7% of
patients had nodules that were recommended for biopsy [91]. Of
those patients that underwent biopsy, 84% had malignant
nodules (16% false positive- but this represented only 0.42%
of the total study population) [91]. In that study, all
spiculated nodules were malignant [91].
1- Clearly benign: Patients with negative scans or obviously benign lesions (calcified granulomas) can be followed with yearly screening.
2- Clearly malignant: Patients
with nodules that have CT characteristics suggestive of
malignancy (spiculated or lobulated margins (lobulated margins
indicates asymmetric growth), air-brochogram sign), should
have the lesion resected. A poorly defined nodule border
confers a 6.6 fold increased risk of lung cancer [103].
3- Indeterminate: An indeterminate nodule is solid, smooth-edged, and does not show characteristically benign calcifications. Small ground-glass nodules and mixed nodules (with solid and ground-glass components) can also be considered in this category. The risk of cancer in a non-solid nodule increases with lesion size, particularly the solid component [45]. According to ELCAP data, 18% of nodules with pure ground glass opacity were malignant, and 63% of nodules with mixed ground-glass opacity were malignant [44]. Subsequently, data from screening studies revealed part-solid nodules on 5% of baseline screening exams (as opposed to solid nodules which are found on 30% of baseline screening exams)- about 2.7% of these proved to be malignant and 20% resolved or decreased in size at followup [101]. A new part solid nodule can be identified at 0.8% of annual repeat screening and about 1.5% prove to be malignant, whereas almost 70% resolve or decrease in size [101]. Patients with indeterminate nodules will require serial CT evaluation for stability. The follow-up interval for indeterminate nodules is often dictated by the individual subject and their physician. Sites experienced in lung cancer screening have adopted the following strategy based on the diameter of the nodule.
A. Nodule less than 5 mm: The likelihood for malignancy in nodules less than 5 mm in size is low [45,51]. Available data indicate that less than 1% of nodules under 5 mm are malignant [54]. Nodules less than 3 mm in diameter have only a 0.2% chance of being malignant, while the risk of malignancy is 0.9% for nodules 4-7 mm in diameter [78].
B. Nodules or mixed nodules between 5 to10 mm: Thin slice helical CT at 3, 6, 12 and 24 months. Short term follow up scans at 3 and 6 months may be confined to the lesion only to decrease patient radiation exposure. Partially solid nodules have the highest probability of malignancy (40-50% in some studies) [78]. Biopsy/removal of nodules that increase in size is recommended (25-30% malignant). Nodules that do not grow in volume in 6 months have a smaller risk of malignancy (less than 10%) [45].
C. Ground glass nodule: Non-solid nodules can be found in up to 4% of baseline screening exams and develop on approximately 0.7% of followup screening studies [96]. Pure ground glass nodules have a higher likelihood for representing a malignancy (about 34%) [78]. Partially solid nodules are even more likely to be malignant [97]. In one study, 63% of semi-solid nodules (with a ground-glass component) were found to be malignant [98]. Pure ground glass nodules tend to grow slowly with volume doubling times of approximately 800 days [78]. Some authors recommend followup of pure ground glass nodules (even new GG nodules that develop on followup screening exams) with one year intervals [96]. However, the recommendations vary [96]. Some authors have suggested that the term indolent lesion of epithelial origin be used to describe GG nodules, rather than the term lung cancer [96]. Focal ground glass nodules can also represent inflammation, atypical adenomatous hyperplasia, and focal interstitial fibrosis [84].
D. Nodules larger than10 mm: Consider biopsy of all of these nodules (30-80% malignant)- the risk of malignancy increases to 18% for nodules 8-20mm, and 50% for those larger than 20 mm [78]. If of adequate size, these nodules may be studied with PET scanning or with CT contrast enhancement. Unfortunately, because bronchoalveolar cell carcinoma is often PET-negative, PET scans should be discouraged if the nodule is predominantly ground-glass [49].
For patchy or non-solid nodules, a short term 6-8 week follow-up CT may sometimes be performed following a course of antibiotics to assess for nodule resolution as a large percentage of these nodules will resolve [45,76].
4- Cancer associated with cystic airspaces: The cysts
associated with lung cancer demonstrate wall thickening, ground
glass attenuation, and mural nodularity which may slowly evolve
over time which necessitates long term followup [108]. Cancer
associated with cystic spaces is most commonly adenocarcinoma
(88% of cases) and it can be seen in both smokers and
non-smokers (up to one-tthird of patients) [108].
Limitations of Screening CT:
A. Incidental nodules: The identification of small non-calcified nodules is becoming so common that the suspicion raised by such a finding is becoming negligible [36]. One or more non-calcified nodules can be detected in 51% to 92% of screened patients [27,34,78], but only approximately 1% of these nodules prove to be malignant (i.e.: 99% of nodules identified are false-positive findings) [18,27]. This high false positive rate leads to increased patient anxiety, and additional medical costs related to CT scans, biopsy, and surgical intervention [18]. Incidental findings which require further evaluation or medical action can be detected in up to 14% of patients- again, increasing costs. Investigators have reported that up to 12% of people who are screened for lung cancer with CT undergo invasive biopsies that ultimately reveal one or more benign processes [66].
B. Missed cancer: Lung cancers can be missed on screening CT
exams due to detection or interpretation errors [29]. Between
32% to 56% of cancers can be missed on initial screening exams
[7,12,29,95]. Up to 23% of cancers are identified, but ot
classified as malignant [95]. These lesions are often very small
(less than 1 cm), not well defined (ground glass attenuation),
or are overlapped with, obscured by, or similar in appearance to
normal structures [29,55]. Cancers are also more commonly missed
due to interpretation errors in patients with underlying lung
disease (with scarring or fibrosis) [29,55,71]. Generally, when
detected on follow-up exams, the lesions are still Stage I,
however, up to 17-18% can be beyond stage I [95]. Another
limitation of screening is that unaided intra- and interobserver
agreement in detecting pulmonary nodules on low dose CT of the
lungs is relatively low [52,72] and there is wide variation as
to what is classified as a pulmonary nodule [72]. Thinner
collimation for screening exams (5 to 8mm) and automatic
computer aided nodule detection programs can improve
identification of nodules that would otherwise go undetected
[29,30,31,55,59]. These programs work best with thin slices
images and a small reconstruction interval [50]. The one
drawback of automated detection systems are that some
nodules/cancers will still not be detected (up to 27% [59]) and
there are a large number of false-positive findings (from 3 to
13 per CT study) [59]. Most missed nodules on computer aid
detection are small (under 4 mm), have low attenuation, and are
not completely surrounded by lung parenchyma [59]. Double
reading has been shown to result in the detection of 2.7% more
cancers and 19% more nodules, but this was not statistically
significant [90]. Computer aided detection (CAD) has been shown
to be useful for the detection of small nodules, but the
drawback is a very large number of false positives [100]. In one
study, CAD systems detected up to 56-70% of small cancers that
were not detected by the radiologist [100]. However, in this
same study, CAD failed to detect 20% of cancers that were
identified by the radiologist [100]. There is also wide
performance variability between different CAD systems [100].
C. Measuring lesion growth: Another limitation of the exam is the difficulty in accurately measuring the growth of small nodules. Two-dimensional CT measurements have been shown to be unreliable in assessing for small changes in lesion size [39,41]. This is because a doubling in volume amounts to only a 26% increase in nodule diameter and a significant change in size may be difficult to appreciate for a small nodule [57]. For example, a 5 mm nodule can double in volume, but its diameter will increase by only 1.25 mm (well within the error of a transaxial measurement [39]). Volumetric nodule reconstructions provide better detection of lesion growth (particularly in the z-axis) and remove the guess work of image registration between separate examinations [19,23,35,41]. Generally, volumetric measurements show good interobserver measurements [58]. However, even automated volumetric measurements can vary considerably- particularly for small nodules (under 5 mm in size), those of ground-glass attenuation [38,58,62,79], and those with spiculated margins [65]. In particular, cardiac pulsations, patient motion, and variations in breath hold can affect the accuracy of volumetric measurements [38,43,79]. Nodule location can also affect the volume measurement- juxtapleural and juxtavascular nodules have been shown to exhibit greater volume measurement variability compared to completely intra-parenchymal nodules [65]. Image compression of greater than 20:1 can also affect the accuracy of volume measurements- particularly for ground-glass nodules [53]. Section thickness and varying the window center can also affect the volume measurement [46,48,65]. Nodules located near the heart show as much as 34% volume change during the cardiac cycle [79]. ECG-gated CT imaging may aid in determination of nodule volume by decreasing pulsation artifacts [43]. There is also significant variability in lesion size and volume observed on serial scanning of the same nodule [58,79]. For this reason, even when applying volumetric analysis, a threshold change in volume must be established for true nodule growth [40,79].
D. Stability over time: Although many people quote that lesion stability over a two year period indicates that the nodule is benign, this statement was taken out of content from the original article in which it appeared. Caution must be used when applying this criteria to pulmonary nodules [13]. In fact, no growth over a two year period has a positive predictive value for benignity of only 65% (sensitivity is 40%, and specificity is 72%) [13]. All two year stability implies is that the lesion has a doubling time of at least 730 days (most malignant lesions have doubling times between 20 and 400 days) [13]. Bronchoalveolar cell carcinoma is particularly problematic as the lesion may appear stable for a period of 2 to 7 years before the diagnosis of BAC is made [14]. In one lung cancer screening study, 13 of 48 cancers (27%) had volume doubling times of longer than 400 days [69]. These data support extended follow-up for small nodules- even non-solid nodules [54].
E. Cancers that develop in the interval between screening
exams: The benefit of screening for lung cancer is to detect
stage I lesions. Because lung cancer can have a wide variation
in doubling times (from 32 days to over 1000 days in one study
[23]), new cancers can arise between screening exams.
In the International Early Lung Cancer Action Program, new nodules were detected in about 5% of patients and of these, 5% were found to be malignant [102]. In the national lung screening trial (NLST), new nodules developed in about 3% of patients [102]. Of these nodules, about 6% were malignant and the risk for malignancy increased with nodule size (from 1.1% for nodules < 4 mm, 13% for nodules ≥ 8 mm, and 24% for nodules ≥ 20 mm) [102]. Because survival is related to stage, it is also important to know what percentage of interval cancers are stage I. Some authors note that up to 23% of cancers are not visible on a previous screening exam and of these, up to 29% can be beyond stage I when detected [95]. Other authors indicate that during follow-up screening, pooled US data indicates that about 60% of cancers detected after the initial prevalence screening exam are stage I, meaning up to 40% are higher stage [74]. Additionally, in the NLST, cancers associated with new nodules had a significantly poorer survival compared to cancers detected at baseline screening likely due to more rapid growth and aggressive characteristics [102,103]. In one study, based upon doubling times- annual screening would result in detection of 94% of T1 tumors, while biennial screening would have detected only 78% of tumors at this size [23]. This suggests that caution and further research are needed prior to changing the screening interval to more than 12 months [95].
|
Rapidly enlarging lung cancer: The patient shown below was being followed for small lung nodules and prominent mediastinal lymph nodes. A chest CT in 2/2006 (left image) was stable to prior exams. A follow-up chest CT 10 months later (12/2006- right image) revealed a new, lung cancer in the right upper lobe. Extensive metastatic disease had already occurred. Such rapidly growing cancers may not be detected on screening CT exams. The small lung nodules (not shown) were again noted to be unchanged. |
|
|
In a retrospective study, it has also been shown that high-risk
patients have a very high incidence of lung cancer developing
even after a series of three prior negative lung screen CT exams
(median of 7 years since completing prior screening and a lung
cancer prevalence of up to almost 21%) ][105]. In that study,
when the previous screening CT exams were reviewed, 43% of the
malignancies had nodules (5-11mm) at the tumor site that had
remained stable during a minimum 2 year interval [105].
F. Screening Bias- survival versus mortality: Screening trials suffer from several forms of bias which can affect survival data, but not generally impact on patient mortality. These include over-diagnosis bias, length bias, and lead-time bias [68]. In over diagnosis bias cancers are detected that might never have become symptomatic during a patient's lifetime because of competing causes of mortality- in other words coexisting heart disease might have resulted in the patient's death prior to the development of symptomatic lung cancer [68]. In length bias (related to tumor aggressiveness), expected survival appears increased by detecting more patients with less aggressive disease (who have longer survival) and fewer patients with more aggressive disease- hence, there appears to be a survival benefit from the screening test [68,74]. Slowly progressing lesions are disproportionately detected at screening due to a longer window for detection [80]. A lead-time bias occurs when patients are accorded extended survival times solely because cancer was detected earlier due to screening, though death occurred at the same time as would have happened without screening (i.e.: the intervention yields no benefit) [68]. For example, if a patient is diagnosed with lung cancer in 2010 and dies from lung cancer in 2013 their survival is three years. If that same patient had undergone screening in 2007 and the cancer had been detected and removed, but they still died from lung cancer in 2013, their survival would be increased to 6 years, but their mortality did not change.
Although detecting lung cancer at an earlier stage will obviously result in improve patient survival, studies have not yet demonstrated a decrease in mortality with lung cancer screening [66,68]. The study by Bach et al [66] revealed that screened patients were diagnosed with lung cancer in far greater numbers than would have occurred in the absence of screening and the majority (67%) were stage I or stage II. However, there was no decrease in overall mortality based upon predicted models [66]. Granted, the study has limitations as the mortality estimates depend on the validity of prior risk factor analyses [66]. Contradicting the Bach model, the Mayo clinic predicted that screening may reduce lung cancer specific mortality (8% reduction in lifetime lung cancer mortality after 5 screening exams) [77]. To date, no study has included a "no screening" comparison group which would permit determination of the true effect of screening on mortality without screening biases [68,77]. Additionally, because of the small number of patients in Bach study, the 95% confidence interval for their data might allow for a lung cancer mortality reduction as large as 30% [66].
G. Surgical complications: Surgical intervention even in early stage lung cancer carries definite risks. In the I-ELCAP study mortality following lung cancer resection was only 0.5% [67]. However, the average mortality in the US following lung cancer resection is 5% (1% when done by an experienced thoracic surgeon [74]), and the frequency of serious complications ranges from 20-40% [66].
H. Incidental findings: Other incidental findings that merit
further evaluation occur in 14-49% of patients including other
neoplasms, adrenal, renal and liver masses, vascular aneurysms,
and coronary artery calcifications [68]. Studies have shown that
a coronary calcium score derived from the lung screen CT exam
can carry prognostic significance regarding all-cause mortality
(with a strong association between an increasing calcium score
and cardiovascular events and all-cause mortality) [93]. These
findings lead to additional health care costs. However, when
viewed from a different perspective, the detection of clinically
significant additional findings can result in early
intervention. Extra-pulmonary malignancies are detected in 0.5
to 1.1% of patients- most commonly renal cancers and lymphoma
[86]. The detection of significant coronary artery
calcifications on screening CT has been shown to be associated
with an increased risk for cardiovascular death and all-cause
mortality [83,92].
I. Additional obligations on the
radiologist: Patients must be understand that a negative
screen does not preclude the subsequent development of lung
cancer, even between scans and that some lung cancers may not
be detected by CT screening. A mechanism must be in place that
ensures the patient is contacted with results of the CT exam.
Appropriate physicians need to be available to council and
treat the patient with a positive result. Patients need to
understand that a large number of small lung nodules are
benign and they must be willing to following screening
guidelines should a nodule be detected. Finally, patients must
be aware that screening is not a "one time" exam, but rather a
process that requires them to submit to yearly evaluation.
J. Patient compliance: Patients
with negative baseline scans and patients that continue to
smoke have been shown to be less compliant with followup
examinations (adherence to followup below 50%) [109].
Conclusion:
CT is clearly superior to chest radiographs for the detection of lung cancer- particularly early stage (Stage IA) lesions [19]. Unfortunately, all lung cancer screening studies lack a control group, so they suffer from screening biases. Regardless of these limitations, survival for Stage IA tumors can be as high as 80% at 5 years. Therefore early detection of lung cancers should lead to overall improved lung cancer survival. The exam may be cost effective with suitable specifications for screening (the cost per life-year saved can be as low as $10,000) [7]. This is below the cost for existing screening programs for and cervical carincoma [7]. However, the cost benefit is directly related to the prevalence of the disease in the screened patient population and higher estimates have also been determined [74]. One should also bear in mind that not all other screening examinations which are currently employed have been shown to result in a survival benefit. Although prostate cancer screening is in widespread use, it is not yet validated for providing a clear benefit in terms of reducing mortality from prostate cancer [35]. Unfortunately, if you screen for lung cancer, you will miss lung cancer in up to 56% of cases [7].
Patients at risk for lung cancer should make their own
decisions regarding their need for CT lung cancer screening
after consultation with a physician [35]. Patients need to
understand that screening is not a "one-time exam", but rather a
yearly requirement if it is to be implemented properly and that
cancers can be missed even on CT imaging. Annual screening for
at risk patients has been recommended for 25 years [102].
REFERENCES
1. Chest 1996; Arita T, Matsumoto T, Kuramitsu T, et al. Is it possible to differentiate malignant mediastinal nodes from benign nodes by size? Reevaluation by CT, transesophageal echocardiography, and nodal specimen. 110: 1004-08
2. J Clin Onc 1998; Eberhardt W, Wilke H, Stamatis G, et al. Preoperative chemotherapy followed by concurrent chemoradiation therapy based on hyperfractionated accelerated radiotherapy and definitive surgery in locally advanced non-small cell lung cancer: Mature results of a phase II trial. 16: 622-34
3. J Thorac Imag 1999; Bepler G. Lung cancer epidemiology and genetics. 14: 228-234
4. Lancet 1998; Sone S, et al. Mass screening for lung cancer with mobile spiral computed tomography scanner. 351: 1242-1245
5. Br J Cancer 2001; Sone S, et al. Results of three-year mass screening programme for lung cancer using mobile low-dose spiral computed tomography scanner. 84: 25-32
6. Lancet 1999; Henschke CI, et al. Early lung cancer action project: overall design and findings from baseline screening. 354: 99-105
7. Cancer 2001; Henschke CI, et al. Early lung cancer action project. Initial findings on repeat screening. 92: 153-159
8. Radiol Clin North Am 2000; Henschke CI, Yankelevitz DF. CT screening for lung cancer. 38: 487-495
9. Cancer 2000; Okamoto N. Cost-effectiveness of lung cancer screening in Japan. 89: 2489-2493
10. Cancer 2000; Kanedo M, et al. Computed tomography screening for lung carcinoma in Japan. 89(11 Suppl):2485-8
11. Radiology 1996; Kaneko M, et al. Peripheral lung cancer: screening and detection with low-dose spiral CT versus radiography. 201:798-802
12. Radiology 1999; Kakinuma R, et al. Detection failures in spiral CT screening for lung cancer: analysis of CT findings. 212: 61-66
13. AJR 1997; Yankelevitz DF, Henschke CI. Does 2-year stability imply that pulmonary nodules are benign. Feb 168 (2): 325-328 (No abstract available)
14. Chest 1998; Dumont P, et al. Bronchoalveolar carcinoma: histopathologic study of evolution in a series of 105 surgically treated patients. Feb;113(2):391-395
15. J Thorac Cardiovasc Surg 1998; Inoune, et al. Diagnositc assessment of 1310 patients with non-small cell lung cancer who underwent complete resection from 1980-1993; 116: 407-411
16. Chest 1999; Adebonjo SA, et al. Impact of revised stage classification of lung cancer on survival. A military experience. 115: 1507-1513
17. Chest 1997; Mountain CF. Revisions in the international system for staging lung cancer. 111: 1710-17
18. Society of Thoracic Radiology Course Syllabus 2000; Swenson SJ. Lung cancer screening: Low dose CT. 32-36
19. AJR 2000; Boiselle PM, et al. Lung cancer detection in the 21st century: Potential contributions and challenges of emerging technologies. 175: 1215-1221 (No abstract available)
20. Radiology 2001; Patz EF, et al. CT screening for lung cancer: not ready for routine practice. 221: 587-591
21. AJR 2002; Diederich S, et al. Screening for early lung cancer with low dose spiral CT: prevalence in 817 asymptomatic smokers. 222: 773-781
22. AJR 2002; Henschke CI, et al. CT screening for lung cancer: frequency and significance of part-solid and nonsolid nodules. 178: 1053-1057
23. Radiology 2002; Winer-Muram HT, et al. Volumetric growth rate of stage I lung cancer prior to treatment: serial CT scanning. 223: 798-805
24. Chest 2002; Nawa T, et al. Lung cancer screening using low-dose spiral CT. Results of baseline and 1-year follow-up studies. 122: 15-20
25. AJR 2002; CT screening: why I do it. Brant-Zawadzki M. 179: 319-326
26. AJR 2002; Prasad SR, et al. Standard-dose and 50%-reduced-dose chest CT: comparing the effect on image quality. 179: 461-465
27. AJR 2002; Swensen SJ. CT screening for lung cancer. 179: 833-836
28. Radiology 2002; Garg K, et al. Randomized controlled trial with low-dose spiral CT for lung cancer screening: feasibility study and preliminary results. 225: 506-510
29. Radiology 2002; Li F, et al. Lung cancers missed at low-dose helical CT screening in a general population: comparison of clinical, histopathologic, and imaging findings. 225: 673-683
30. Radiology 2002; Armato SG, et al. Lung cancer: performance of automated lung nodule detection applied to cancers missed in a CT screening program. 225: 685-692
31. Radiology 2003; Brown MS, et al. Lung micronodules: automatic method for detection at thin-section CT- initial experience. 226: 256-262
32. Radiology 2003; Shah PK, et al. Missed non-small cell lung cancer: radiographic findings of potentially resectable lesions evident only in retrospect. 226: 235-241
33. Radiology 2003; Earnest F, et al. Respecting patient autonomy: screening at CT informed consent. 226: 633-634
34. Radiology 2003; Swensen SJ, et al. Lung cancer screening with CT: Mayo clinic experience. 226: 756-761
35. Thorax 2002; Mulshine JL, Smith RA. Lung cancer 2: screening and early diagnosis of lung cancer. 57: 1071-1078
36. Radiology 2004; Henschke CI, et al. C screening for lung cancer: suspiciousness of nodules according to size on baseline scans. 231: 164-168
37. Radiology 2004; Brenner DJ. Radiation risks potentially associated with low-dose CT screening of adult smokers for lung cancer. 231: 440-445
38. Radiology 2004; Kostis WJ, et al. Small pulmonary nodules: reproducibility of three-dimensional volumetric measurement and estimation of time to follow-up CT. 231: 446-452
39. Radiology 2004; Revel MP, et al. Are two-dimensional CT measurements of small noncalcified pulmonary nodules reliable? 231: 453-458
40. Radiology 2004; Revel MP, et al. Pulmonary nodules: preliminary experience with three-dimensional evaluation. 231: 459-466
41. Radiology 2004; Jennings SG, et al. Lung tumor growth: assessment with CT- comparison of diameter and cross-sectional area with volume measurements. 231: 866-871
42. Radiology 2004; Tiggers S, et al. Routine chest radiography in a primary care setting. 233: 575-578
43. Radiology 2004; Boll DT, et al. Volumetric assessment of pulmonary nodules with ECG-gated MDCT. 233: 1217-1223
44. Radiology 2004; Li, F, et al. Malignant versus benign nodules at CT screening for lung cancer: comparison of thin-section CT findings. 233: 793-798
45. Chest 2004; Libby DM, et al. Managing the small pulmonary nodule discovered by CT. 125: 1522-1529
46. Radiology 2005; Zhao B, et al. Pulmonary metastases: effect of CT section thickness on measurement- initial experience. 234: 934-939
47. Radiology 2005; Swensen SJ, et al. CT screening for lung cancer: five-year prospective experience. 235: 259-265
48. Radiology 2005; Goo JM, et al. Volumetric measurement of synthetic lung nodules with multi-detector row C: effect of various image reconstruction parameters and segmentation threshold on measurement accuracy. 235: 850-856
49. AJR 2005; Lindell RM, et al. Lung cancer screening experience: a retrospective review of PET in 22 non-small cell lung carcinomas detected on screening CT in a high-risk population. 185: 126-131
50. Radiology 2005; Kim JS, et al. Automated detection of pulmonary nodules on CT images: effect of section thickness and reconstruction interval- initial results. 236: 295-299
51. Radiol Clin N Am 2005; Hartman TE. Radiologic evaluation of the solitary pulmonary nodule. 43: 459-465
52. AJR 2005; Leader JK, et al. Pulmonary nodule detection with low-dose C of the lung: agreement among radiologists. 185: 973-978
53. Radiololgy 2005; Ko JP, et al. Effect of CT image compression on computer-assisted lung nodule volume measurement. 237: 83-88
54. Radiology 2005; MacMahon H, et al. Guidelines for management of small pulmonary nodules detected on CT scans: a statement from the Fleischner society. 237: 395-400
55. Radiology 2005; Li F, et al. Computer-aided detection of peripheral lung cancers missed at CT: ROC analysis without and with localization. 237: 684-490
56. Radiology 2006; Gur D. Lung cancer screening: radiology's opportunity here and now. 238: 395-397
57. J Nucl Med 2006; Bunyaviroch T, Coleman RE. PET evaluation of lung cancer. 47: 451-469
58. AJR 2006; Goodman LR, et al. Inherent variability of CT lung nodule measurements in vivo using semiautomated volumetric measurements. 186: 989-994
59. AJR 2006; Yuan R, et al. Computer-aided detection in screening CT for pulmonary nodules. 186: 1280-1287
60. AJR 2006; Revel MP, et al. Software volumetric evaluation of doubling times for differentiating benign versus malignant pulmonary nodules. 187: 135-142
61. AJR 2006; Mascalchi M, et al. Risk-benefit analysis of x-ray exposure associated with lung cancer screening in the Itallung-CT trial. 187: 421-429
62. Radiology 2006; Gietema HA, et al. Pulmonary nodules detected at lung cancer screening: interobserver variability of semiautomated volume measurements. 241: 251-257
63. AJR 2006; Kakeda S, et al. Effect of temporal subtraction technique on interpretation time and diagnostic accuracy of chest radiography. 187: 1253-1259
64. Radiology 2006; Boone JM. Multidetector CT: opportunities, challenges, and concerns associated with 64 or more detector rows. 241: 334-337
65. AJR 2007; Petrou M, et al. Pulmonary nodule volumetric measurement variability as a function of CT slice thickness and nodule morphology. 188: 306-312
66. JAMA 2007; Bach PB, et al. Computed tomography screening and lung cancer outcomes. 297: 953-961
67. JAMA 2007; Black WC, Baron JA. CT screening for lung cancer. Spiraling into confusion? 297: 995-997
68. Thorax 2007; Black C, et al. Population screening for lung cancer using computed tomography, is there evidence of clinical effectiveness? A systemic review of the literature. 62: 131-138
69. Radiology 2007; Lindell RM, et al. Five-year lung cancer screening experience: CT appearance, growth rate, location, and histologic features of 61 lung cancers. 242: 555-562
70. Radiology 2007; NY Early Lung Cancer Action Project. CT screening for lung cancer: diagnoses resulting from the New York early lung cancer action project. 243: 239-249
71. Radiographics 2007; Park CM, et al. Nodular ground-glass opacity at thin-section CT: histologic correlation and evaluation of change at follow-up. 27: 391-408
72. Radiology 2008; Gierada DS, et al. Lung cancer: interobserver agreement on interpretation of pulmonary findings at low-dose CT screening. 246: 265-272
73. Radiology 2008; Li F, et al. Lung cancers missed on chest radiographs: results obtained with a commercial computer-aided detection program. 246: 273-280
74. AJR 2008. Ravenel JG, et al. Screening for lung cancer. 190: 755-761
75. AJR 2008. Li F, et al. Improved detection of small lung cancers with dual-energy subtraction chest radiography. 190: 886-891
76. Chest 2006; Libby DM, et al. CT screening for lung cancer. The value of short-term CT follow-up. 129: 1039-1042
77. Radiology 2008; McMahon PM, et al. Estimating long-term effectiveness of lung cancer screening in the Mayo CT screening study. 248: 278-287
78. Radiology 2009; Xu DM, et al. Smooth or attached solid indeterminate nodules detected at baseline CT screening in the NELSON study: cancer risk during 1 year of followup. 250: 264-272
79. AJR 2009; Rampinelli C, et al. In vivo repeatability of automated volume calculations of small pulmonary nodules with CT. 192: 1657-1661
80. Radiology 2010; Pickhardt PJ, et al. Colorectal and extracolonic cancers detected at screening CT colonography in 10286 asymptomatic adults. 255: 83-88
81. Radiology 2010; de Hoop B, et al. Screening for lung cancer with digital chest radiography: sensitivity and number of secondary work-up examinations. 255: 629-637
82. Radiology 2010; de Hoop B, et al. Computer-aided detection of lung cancer on chest radiographs: effect on observer performance. 257: 532-540
83. Radiology 2010; Shemesh J, et al. Ordinal scoring of coronary artery calcifications on low-dose CT scans of the chest is predictive of death from cardiovascular disease. 257: 541-548
84. AJR 2011; Goo JM, et al. Ground-glass nodules on chest CT
as imaging biomarkers in the management of lung adenocarcinoma.
196: 533-543
85. Radiology 2011; Freedman MT, et al. Lung nodules: improved
detection with software that supprresses the rib and clavicle on
chest radiographs. 260: 265-273
86. Radiology 2011; Rampinelli C, et al. Extrapulmonary
malignancies detected at lung cancer screening. 261: 293-299
87. JAMA 2011; Oken MM, et al. Screening by chest radiograph
and lung cancer mortality. The prostate, lung colorectal, and
ovarian (PLCO) randomized trial. 306: 1865-1873
88. N Engl J Med 2011; National lung screening trial research
team, Aberle DR, et al. Reduced lung-cancer mortality with
low-dose computed tomographic screening. 365: 395-409
89. AJR 2011; Larke FJ, et al. Estimated radiaiton dose
associated with low-dose chest CT of average-sized participants
in the national lung screening trial. 197: 1165-1169
90. Radiology 2012; Wang Y, et al. No benefit for consensus
double reading at baseline screening for lung cancer with the
use of semiautomated volumetry software. 262: 320-326
91. AJR 2012; Wagnetz U, et al. CT screening for lung cancer:
implication of lung biopsy recommendations. 198: 351-358
92. Radiology 2012; Sverzellati N, et al. Relationship and
prognostic value of modified coronary artery calcium score,
FEV1, and emphysema in lung cancer screening population: the
MILD trial. 262: 460-467
93. AJR 2012; Jacobs PC, et al. Coronary artery calcium can
predict all-cause mortality and cardiovascular events on
low-dose CT screening for lung cancer. 198: 505-511
(94) AJR 2013; Kim YK, et al. Reduced radiation exposure of the
female breast during low-dose chest CT using organ-based tube
current modulation and a bismuth breast shield: comparison of
image quality and radiation dose. 200: 537-544
(95) AJR 2014; Xu DM, et al. Retrospective review of lung
cancers diagnosed in annual rounds of screening. 203: 965-972
(96) Radiology 2015; Yankelevitz DF, et al. CT screening for
lung cancer: nonsolid nodules in baseline and annual repeat
rounds. 277: 555-564
(97) Radiology 2006; Winer-Muram HT. The solitary pulmonary
nodule. 239: 34-49
(98) Radiol Clin N Am 2005; Hartman TE. Radiologic evaluation
of the solitary pulmonary nodule. 43: 459-465
(99) J Am Coll Radiol 2015; McKee BJ, et al. Experience with a
CT screening program for individuals at high risk for developing
lung cancer. 12: 192-197
(100) Radiology 2016; Liang M, et al. Low-dose CT screening for
lung cancer: computer-aided detection of missed lung cancers.
281: 279-288
(101) AJR 2016; Henschke CI, et al. CT screening for lung
cancer: part-solid nodules in baseline and annual repeat rounds.
207: 1176-1184
(102) AJR 2017; Pinsky PF, et al. Lung cancer risks associated
with new solid nodules in the national lung screening trial.
209: 1009-1014
(103) Radiology 2018; Liu Y, et al. Radiologic features of
small pulmonary nodules and lung cancer risk in the national
lung screening trial: a nested case-control study. 286: 298-306
(104) AJR 2018; Carter BW, et al. Screening for lung cancer:
lexicon for communicating with health care providers. 210:
473-479
(105) Radiology 2018; Kavanagh J, et al. Importance of
long-term low-dose follow-up after negative findings at previous
lung cancer screening. 289: 218-224
(106) Radiology 2019; Hammer MH, et al. Cancer risk in subsolid
nodules in the National Lung Screening Trial. 293: 441-448
(107) Radiology 2020; Godoy MCB. Conservative management of
juxtapleural nodules at low-dose CT lung cancer screening: is
this proudent? 297: 719-720
(108) AJR 2021; Mendoza, D, et al. Clinicopathologic and
longitudinal imaging features of lung cancer associated with
cystic airspaces: a systemic review and meta-analysis. 216:
318-329
(109) AJR 2021; Barbosa EJM, et al. Real-world lung cancer
screening performance, smoking behavior, and adherence to
recommendations: Lung-RADS category and smoking status predict
adherence. 216: 919-926